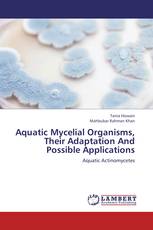
Aquatic Mycelial Organisms, Their Adaptation And Possible Applications

Punica granatum Linn
Evaluation of Antidiabetic and Antiulcer Activity
Rupesh K. Gautam - ISBN: 978-3-659-23110-0
Application of Hightech Agriculture to overcome disasters in agri
High Tech Agriculture (Micro Irrigation, Mulching and Green Houses)
Dhiren Vandra - ISBN: 978-3-659-21066-2
Substance abuse and affluence
social determinants influencing substance misuse behavior among affluent adults
Pankaj Thomas - ISBN: 978-3-659-23294-7
Доверительное управление имуществом в сфере предпринимательства
Научная монография в области предпринимательского права России
Злата Беневоленская - ISBN: 978-3-659-22440-9
Руководство по совершенствованию английского языка
Сценарии нетрадиционных форм уроков и внеаудиторных мероприятий
Галина Походзей - ISBN: 978-3-659-21852-1
Civil Society, Women’s Movement and the Moroccan State
Addressing the Specificities and Assessing the Roles
Mohammed Yachoulti - ISBN: 978-3-659-22069-2
FlowShop scheduling techniques
Idle Waiting Time Operator
Deepak Gupta, Harminder Singh, Sameer Sharma - ISBN: 978-3-659-22827-8
Aquatic Mycelial Organisms, Their Adaptation And Possible Applications
Aquatic Actinomycetes
Tania Hossain, Mahbubar Rahman Khan - ISBN: 978-3-659-22325-9
Where can you catch botulism food poisoning?
Foodborne botulism
Alcides Troncoso, Cecilia Ramos Clausen, Jessica Rivas - ISBN: 978-3-659-23295-4
Lobbying in Old and New Europe
Understanding Practices and Perceptions in the European Parliament
Justyna Nytko - ISBN: 978-3-659-22299-3